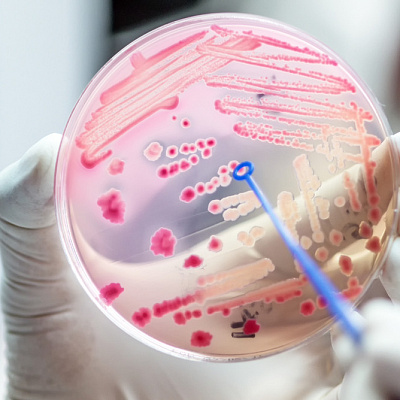

Импетиго у детей
Импетиго у детей — это нередкая причина родительской паники. Сложно оставаться спокойным, когда на лице малыша появляются пузырьки-гнойнички, после которых остаются мокнущие ранки. Родители тревожатся, ребенок страдает. Из-за серьезного дискомфорта он капризничает, расстраивается сон, не хочется даже самой любимой еды.
Этим заболеванием представлена обширная группа поверхностных пиодермий. Как понятно из названия, воспаление развивается лишь в верхних слоях кожи. Что совсем не отменяет исключительно неблагоприятных последствий. Родители, которые считают себя опытными, начинают самостоятельно решать проблему. Итог — грубые шрамы у малыша, комплексы, переживания. Так что сразу, как только возникло первое пятно, нужно идти к педиатру. На начальном этапе любое заболевание лечить проще и быстрее.

Причины импетиго у детей
Болезнь всегда инфекционная. Ее непосредственной причиной являются разные бактерии, тем или иным путем внедрившиеся в детский организм. Одни патогены, в любом случае вызывают инфекцию. Вторые же — бактерии условно-патогенные. Они всегда есть в организме, ничем себя не проявляют. Но лишь до определенной поры. Стоит немного ослабнуть иммунной защите, как приходит время условных патогенов. Начинается активное размножение, быстро растет их численность, достигая достаточных для воспаления величин.
Главные «виновники» образования гнойничков — безусловно, стафилококки. Бывают они золотистыми, гемолитическими, эпидермальными. Лидируют первые, поражая кожу 9-ти малышей из 10-ти. В роли «помощников» выступают бета-гемолитические стрептококки. Именно такие комбинации наиболее часто встречаются в педиатрической практике. Иногда их дополняют и другие бактериальные разновидности: синегнойная и/или кишечная палочка, протей, пневмококки.
Основываясь на наших наблюдениях, импетиго у детей намного чаще встречается в самом раннем возрасте. Особенно рискуют заболеть груднички. Дело в том, что в отличие от взрослых на их коже обитает мало бактерий. И видов меньше, и популяции относительно небольшие. Нет того самого равновесия между микроорганизмами, благодаря которому быстро и полноценно обезвреживаются патогены, не успев развиться, купируется инфекционно-воспалительный процесс.
Помимо несовершенной иммунной защиты свой вклад вносит и высокая чувствительность кожи. Она нежная, тонкая, много сосудов находится прямо под ней. Роговой слой у малышей настолько проницаем, что его даже сложно, в общем, назвать каким-нибудь барьером. Кератиноциты не спешат вырабатываться, без них слаб водоупорный слой кожи. Она пока непрочная, патогены преодолевают ее без каких-либо проблем.

Предрасполагающие факторы
И стафилококковая, и стрептококковая инфекция быстро распространяется в тесном детском коллективе. Игрушки, книжки и карандаши нередко на время становятся общими. Если здоровый ребенок воспользовался чем-то заразным, то появления высыпаний долго ждать не придется. Не все малыши обязательно заболеют. Обычно заражаются те, что находятся в группе повышенного риска. О каких факторах идет речь:
- Кожные патологии и повреждения. Даже незначительная ссадинка, укус насекомого, миниатюрная трещинка, поверхностный порез — входные ворота для бактерий. Травмы хотя бы вскоре заживают, а вот с сыпью от хронического дерматита приходится сражаться несколько дней. Кожа сильно зудит, малыш не может удержаться, чтобы не чесаться. Теперь помимо папул, пустул, пузырьков есть и микротравмы от ногтей.
- Плохая иммунная защита. Иммунная система с самого рождения может работать с нарушениями. В таких случаях иммунодефицит считается первичным. Вторичный же сохраняется несколько дней или недель, если малыш тяжело переболел инфекцией.
- Сопутствующие хронические болезни. От атак бактерий и вирусов всегда страдают дети, у которых уже диагностирован гипокортицизм или сахарный диабет. В группу риска включены и те, у кого в кишечнике недостает полезных бактерий, есть воспаление в желудке, не хватает витаминов, один тонзиллит почти сразу сменяется другим.
А еще в целом полезные лекарства также способны угнетать иммунитет. Самые мощные, распространенные провокаторы — глюкокортикостероиды, иммунодепрессанты, антибиотики для приема внутрь.

Риск заболеть импетиго у детей возрастает в определенные времена года. Жара, зной и подвижные игры — все, что нужно для активного потения. Кожа липкая, влажная, что облегчает проникновение возбудителей через потовые железы и расширенные капилляры. Холод почти так же опасен. Если ребенок много времени проводит на улице, то даже теплая одежда не спасет положения. Растет сухость кожи, образуются микротрещинки. И здесь болезнетворным бактериям не составляет труда внедриться в организм.
Патогенез
Механизм развития стрептококкового импетиго у детей известен. Все дело в наличии у бактерий М-компонента. Действует он против фагоцитов, которые занимаются перевариванием, поглощением чужеродных веществ. Когда их становится меньше, о качественной иммунной защите речи не идет. К тому же стрептококки выделяют множество токсинов, облегчая себе распространение по организму.
У стафилококков роль спускового крючка отведена особым белкам. Чем их больше, тем легче и прочнее бактерии крепятся к коже. А еще они постоянно выбрасывают в окружающее пространство токсичные вещества. Из-за них будет очень долго заживать самый маленький порез. Так что, у стафилококков хватает времени, чтобы внедриться в кожу.
Классификация
Первой классификацией учитывается природа возбудителей. В разные группы выделяют инфекцию стрептококковую, стафилококковую, смешанную (вульгарную). Форм же существенно больше:
- Сухая (лишай Видаля). Розовые пятна преимущественно на лице. Сразу начинается шелушение, долго остаются темные участки.
- Буллезная. Пузыри (буллы) обычно на ногах. Внутри находится жидкость с кровью и гноем. После прорывания пузырька остается плотная корка. Буллезное импетиго у детей всегда приводит к ухудшению общего состояния.
- Кольцевидная. Неравномерно заживающие буллы. Кажется, что после схлопывания кожа начинает восстанавливаться. Однако происходит это только в центральной части. На краях же образуются плотные воспаленные валики.
- Щелевидная. Пузырек сменяется трещиной с красными краями. Классический признак щелевидного импетиго у детей — заеды. Нередки поражаются крылья носа, уголки глаз.
- Сифилоподобная. Сифилис здесь абсолютно не причем. Просто внешний вид высыпаний очень схож с твердым шанкром. Пузырек схлопывается, появляется неглубокая язвочка с очень плотными краями.
- Вегетирующая. Пузырьки сначала формируются на одном участке, а затем поражается все тело.
- Интертригинозная. Связанное только со стрептодермией импетиго у детей. Почти в каждой крупной складке кожа воспалена, ребенок жалуется на боли, невольно сильно расчесывает тело, чтобы избавиться от зуда.
Бывает, что пузырьки расположены только на слизистых оболочках. Глаза, рот, в том числе язык, носовые ходы — традиционные зоны высыпаний. Такая форма называется слизистой.
Симптомы импетиго у детей
Значим тип болезни. Стрептококковая протекает с образованием фликтенов. Таким сложным термином в медицине обозначают пузырьки с дряблыми сферами. Заполнены они мутной жидкостью, нередко с примесями гноя.
При запущенной стрептококковой инфекции высыпаний много около крыльев носа и вокруг рта. Достаточно максиму 4-х дней для вскрытия фликтенов. Оставшиеся желтоватые корочки вскоре отслаиваются. Если пузырек вскрылся сам, то кожа полностью приходит в норму. Но зуд бывает настолько силен, что малыш нечаянно лопает его или сдирает корочку. Тогда могут остаться мелкие шрамы.
Когда инфекция только стафилококковая, то протекает она по типу остиофолликулита. Волосяные фолликулы воспаляются вверху, образуется гнойная полость в форме конуса с волосом внутри. В лучшем случае пустулы единичные, в худшем их появляется очень много. Излюбленная локализация — голова. Спустя несколько дней на месте пустул возникают корочки и вскоре отпадают.
Осложнения импетиго у детей
У 1-го из 20-ти малышей наблюдаются неблагоприятные последствия. Родители сами лечили детей, к врачам обращались при уже сильно запущенном инфекционном процессе. Результат себя ждать не заставил. В коже размножилось столько бактерий, что им стало тесно. Они упорно двигались внутрь, один за другим поражая внутренние органы на своем пути. Типичные и очень опасные последствия системной инфекции:
- сепсис — заражение крови;
- септикопиемия — гнилостно-гнойное заражение крови;
- инфекционно-токсический шок — массивное поступление в кровь бактериальных эндотоксинов (при заражении стафилококками).
Даже внедрившись лишь в глубокие слои кожи, бактерии успевают натворить дел. Самым распространенным осложнением считается абсцесс. Из-за токсинов между слоями кожи образуется полость с пиогенной оболочкой, внутри которой гной. Чуть реже ребенок страдает от карбункулов. Несколько волосяных фолликулов сразу воспаляется, образуется участок темного, почти черного цвета с погибшими тканями.
И, наконец, на третьем месте в рейтинге осложнений расположилась эктима обыкновенная. Возникает обычно при стрептококковом импетиго у детей. Вместо корок появляются труднозаживающие язвы, а потом и рубцы. Именно из-за стрептококков у некоторых малышей во всем теле воспаляются лимфоузлы и/или лимфососуды. Когда лечения нет, нельзя исключать развития острого гломерулонефрита и ревматической лихорадки.
Диагностика
Симптомы весьма яркие, особенно когда локализовано импетиго у детей на лице. Так что первичная диагностика вполне может быть домашней. Но затем все-таки придется посетить клинику, чтобы сдать биообразцы в лабораторию. Впрочем, всегда можно вызвать медсестру. Она возьмет нужный материал и передаст сотрудникам диагностического центра.
Инструментальные исследования не проводятся. Только при тяжелых осложнениях может быть назначен тот или иной вариант визуализации (ультразвуковое сканирование, томография внутренних органов). На первый же план выходят такие методики:
- Физикальный осмотр. Максимально информативен. На импетиго прямо указывают вид и расположение высыпаний. Доктор спросит у родителей, сколько времени прошло с появления симптомов, как тяжело ребенок переносит инфекцию. Дополнительную информацию он получает из истории болезней. Чем их больше, тем слабее иммунитет.
- Микробиологические методики. Бактерии некоторых видов получится отлично рассмотреть под микроскопом. Когда их много, флора отделяемого из высыпаний разнообразная или возбудители чересчур мелкие, не обходится без бакпосева. После нескольких дней пребывания в термостате в чашках Петри образуются колонии. По внешнему виду судят о природе бактерий, по количеству — о тяжести импетиго. Сразу возбудители тестируются на восприимчивость к антибиотикам.
- Гемограмма. Анализ крови может не показать ничего при легком и умеренном течении инфекции. Если малыш сильно страдает, то в образце повышен уровень эритроцитов, увеличена СОЭ.
Педиатру или детскому дерматологу бывает нужна помощь в случае серьезных осложнений. Тогда маленького пациента обследует тандем узкопрофильных специалистов, включая эндокринолога и иммунолога.
Лечение импетиго у детей
Терапия амбулаторная, но грудничок может быть госпитализирован даже при умеренном течении инфекции. В остальных случаях родители дома обрабатывают участки с высыпаниями, дают ребенку таблетки. В клинике же проводятся контрольные обследования.
Чаще всего лечение вначале местное. Что назначается при неосложненной форме импетиго:
- обработки растворами, которые не дают размножаться бактериям и подсушивают поврежденную кожу;
- нанесение мазей, гелей, суспензий, кремов с противомикробными и антибактериальными компонентами;
- использование топических глюкокортикостероидов (при очень сильном воспалении).
Антибиотики придется принимать внутрь, когда есть одно или несколько бактериальных осложнений. В самых сложных случаях их колют в мышцу, реже — вводят внутривенно.
Прогноз и профилактика
Вне осложнений исход всегда благополучный. Очень важно научить ребенка соблюдать личную гигиену. И, прежде всего, мыть руки сразу после возвращения с улицы. Педиатры и дерматологи рекомендуют родителям вплотную заняться укреплением иммунитета своего малыша. Даже если он еще грудничок, необходимы воздушные ванны и полноценное питание.
Любые хронические дерматозы должны своевременно пролечиваться. Как только появились первые признаки обострения, нужно спешить к врачу. Не будет сыпи, не будет и импетиго.
Источники
- Бакстон П. К. Дерматология. - М.: Бином, 2005. - 175 с.
- Тихоновская, И. В. Буллезные дерматозы : метод. рекомендации / И. В. Тихоновская, М. А. Катина. - Витебск: ВГМУ, 2018. - 57 с.
- Современный взгляд на этиопатогенез, клинические проявления и лечение пиодермий у детей/ О.Б. Тамразова, Е.А. Шмелева, А.К. Миронова, Н.Ф. Дубовец // Медицинский совет. — 2020.
- Наружная терапия пиодермии у детей/ И.В. Хамаганова // Лечащий врач. — 2018.
- Pereira L.B. Impetigo - review. An Bras Dermatol. 2014;89(2):293-299. doi: 10.1590/ abd1806-4841.20142283.

Ответы на вопросы
Сколько длится импетиго у ребенка?
При хорошем иммунитете все симптомы исчезнут за одну неделю, при более слабой естественной защите потребуется две. Но пока не бесследно. Примерно около месяца остаются темно-бежевые или розовые пятнышки на местах отслаивания корочек. Если все-таки возникли местные осложнения, терапия затянется на 1-2 месяца. Сколько продлятся лечение и реабилитация после системных, может спрогнозировать только педиатр.
Правда, что импетиго возникает из-за грязных рук?
Правда. Один из базовых факторов риска — плохая гигиена. Дома за ней следят родители, напоминают о большом значении чистых рук. В процессе игр все наставления ребенок забывает. Грязными руками он касается лица, вдыхает или проглатывает мельчайшие частицы слизи, буквально кишащие патогенами.
При импетиго у ребенка сильно болит?
Пораженная кожа очень болезненна. Дети старше 3-х лет специально ограничивают себя в движениях. Груднички пока не могут связать их с усилением боли. Поэтому каждая попытка перевернуться заканчивается громким плачем. И груднички, и дети постарше спят беспокойно, часто просыпаются. От еды отказываются все, ведь жевание приводит к боли.
Каким бывает импетиго при заражении ребенка сразу и стрептококками, и стафилококками?
Воспаление более интенсивное, если в организме малыша стремительно растет численность двух видов бактерий. Кожа отечная, ярко-розовая. Множество пузырей с гноем внутри расположено по всему телу. Прорываются они лишь через неделю, еще дольше остаются плотные темно-желтые корочки.
Заболевания по направлению Детский дерматолог
Лицензии

Мы осуществляем деятельность на основании медицинских лицензий в соответствии с рекомендациями Минздрава